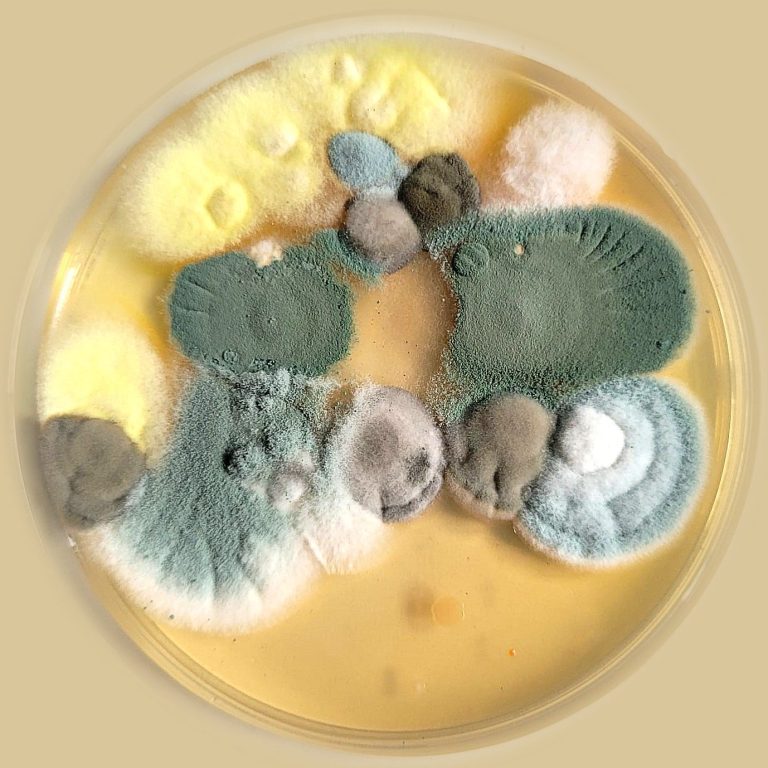

Präzise Schimmelortung auf sechs Pfoten in NRW
Schimmel verdächtigt, aber nicht sichtbar?
Wenn es in der Wohnung muffig riecht oder die Atemwege gereizt sind, liegt der Verdacht nahe: Schimmel.
Doch oft verbirgt sich der Befall unsichtbar hinter Tapeten, Fußleisten oder in der Dämmung. Bevor Sie teure Sanierungen auf gut Glück starten oder Wände großflächig aufreißen, lassen Sie die Profinasen ran.
Unsere professionellen Schimmelspürhunde finden verdeckte Schäden - schnell, effizient und absolut zerstörungsfrei.
Unser Einsatz für Sie
Wir unterstützen Privatpersonen, Vermieter und Hausverwaltungen dabei, Klarheit zu schaffen.
Kostenlose Erstberatung: Wir besprechen am Telefon Ihren Verdacht und klären, ob ein Einsatz sinnvoll ist.
Die Begehung: Unser Team besucht Sie vor Ort. Der Hund sucht konzentriert die betroffenen Bereiche ab.
Klarheit & Empfehlung: Wir markieren die Fundstellen und beraten Sie diskret über die nächsten Schritte.
Warum ein Schimmelspürhund die beste Wahl ist
. Zerstörungsfreie Suche: Keine unnötigen Bohrungen oder abgeschlagenen Fliesen.
. Punktgenaue Ortung: Wir zeigen Ihnen exakt, wo das Problem liegt – das spart massive Sanierungskosten.
. Sicherheit für Ihre Gesundheit: Schimmelsporen können Allergien und Asthma auslösen. Wir finden die Quelle, bevor sie zum dauerhaften Risiko wird.
. Sofortiges Ergebnis: Sie wissen direkt nach der Begehung, ob und wo Handlungsbedarf besteht.

Handeln Sie jetzt – Ihrer Gesundheit zuliebe.
Verlieren Sie keine Zeit bei Schimmelverdacht. Ein frühzeitiges Erkennen schont den Geldbeutel und Ihre Lungen.
